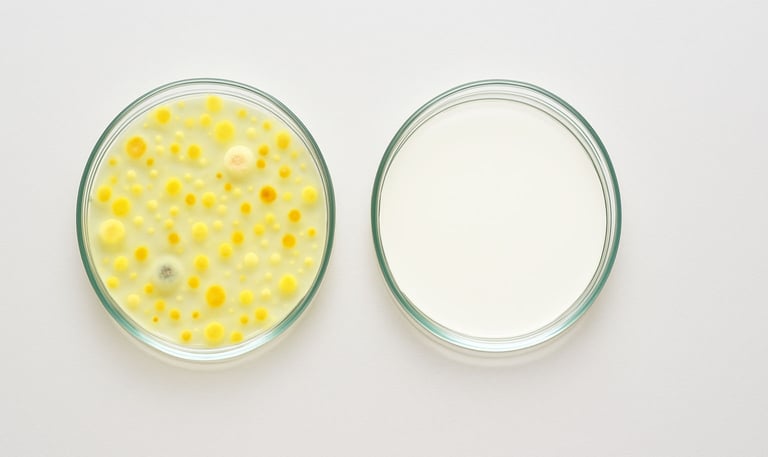
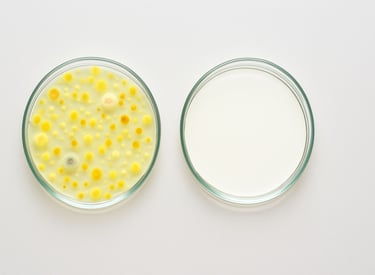

Descontaminación e Higienización de casas y apartamentos
Elimina bacterias, virus y malos olores con tecnología avanzada y certificada para tu seguridad.
Comprometidos con tu salud ambiental
Nos especializamos en descontaminación e higienización de espacios, utilizando tecnologías avanzadas para eliminar bacterias, virus y malos olores, garantizando ambientes seguros y saludables.
Tu bienestar es nuestra prioridad
Tecnología avanzada para limpieza
Ofrecemos análisis microbiológico y soluciones efectivas para mantener tus espacios residenciales y comerciales libres de contaminantes, asegurando un ambiente certificado y saludable para ti y los tuyos.
Servicios de limpieza
Descontaminación y higienización de espacios residenciales y comerciales para un ambiente seguro y saludable.
Limpieza de Muebles y Colchones
El lavado de colchones y muebles es fundamental para mantener un hogar higiénico y libre de impurezas.


Análisis microbiológico
Realizamos análisis microbiológicos para garantizar la seguridad y calidad del aire en su espacio haciendo muestra de ambiente de su espacio y superficie.

Galería




Descubre nuestros servicios de descontaminación y higienización ambiental.
¡Excelente servicio! Biohogar limpió mi casa a fondo, eliminando olores y bacterias. Me siento más seguro y saludable en mi hogar. Totalmente recomendado.
María López
★★★★★
HIGUIENE
Descontaminación y análisis microbiológico de espacios.
CONTACTO
COTIZACIÓN
+57 304 308 7183
